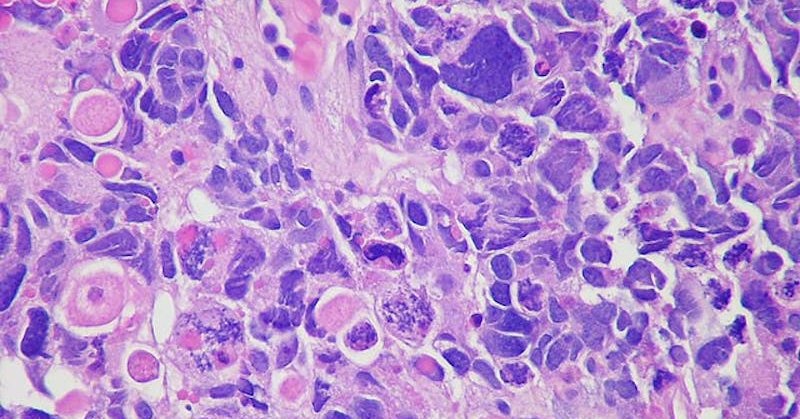
Tweet card summary image

PascaLab
@Pasca_Lab
Followers
2K
Following
6K
Media
21
Statuses
422
Cancer Cell Crosstalk Lab
Ann Arbor, MI
Joined May 2020
My Research Spotlight 🔬 blog this month feat. exciting progress in #pancreaticcancer research, along with a reflection on my visit to D.C. to advocate for federal funding on Capitol Hill: https://t.co/b8Zqyn3IPp
0
3
18
Inspiring write-up on @zeribechike, @NwosuLab. Way to go Zeribe! Around the Globe and Back: Cornell Professor Approaches Cancer Research with an International Perspective @UMRogelCancer, @UMPhysiology, @Pasca_Lab
cornellsun.com
The Cornell Daily Sun - Independent Since 1880.
0
5
16
ICYMI in @CD_AACR: Oncogenic #KRAS-Dependent Stromal Interleukin-33 Directs the Pancreatic Microenvironment to Promote Tumor Growth @KatelynLDonahue @Pasca_Lab
https://t.co/AuMHeFT6ZD
#AACRpan24
1
3
17
Components of normal tissue architecture maintain structure (+ fxn) & serve as barriers to tumor progression…but how? We report a 🧩 in our new preprint. Congrats to 1st author @kathrinaonate & thx to collabs @MSKCancerCenter @OHSUKnight @StanfordMed! 1/ https://t.co/cHuAELP8N5
14
29
125
New preprint from @MaraShermanLab @MSKCancerCenter Stromal KITL/SCF promotes pancreas tissue homeostasis and restrains tumor progression https://t.co/wTXnSUPLNn This study examines what factor(s) in the normal pancreatic mesenchyme might be lost in the process of multistep
1
11
44
Happy to share this opportunity to join our team. Please apply if you are interested, or re-post if you are not on the look out for a new job
0
56
64
Congratulations to Filip Bednar, M.D., on your promotion to Associate Professor of Surgery with Tenure!
4
6
47
Zeribe Nwosu (@zeribechike), assistant professor of molecular biology & genetics, is working to identify & study mechanisms through which #cancer cells acquire & utilize nutrients - currently mainly focused on pancreatic cancer. Follow his lab: @NwosuLab. https://t.co/Q2wi561kMr
1
9
24
Nice to reconnect with @RosaMenjivarPhD former grad student in @Pasca_Lab @KeystoneSymp #KSTumorMetab24
1
4
48
The @NwosuLab still has one pending postdoc position. The new deadline is Jan 31. Please kindly share and encourage prospective candidates to apply.
We have reopened the call for 1 of 2 postdocs in the Nwosu Lab. New deadline is Jan 31. Please kindly RT. In the spirit of the new year, those who applied in 2023 and believe their situation have changed should feel free to send me their updates directly.
1
23
28
Thank you JEM for including my story in the Women in stem interview series! It is a pleasure and honor to be highlighted with these amazing scientists!
At JEM this year we have been highlighting #WomenInSTEM in the #PeopleAndIdeas Interview series. We are so thankful to everyone who contributed, and we would like to share some of the highlights below. Be sure to check out the interviews here: https://t.co/HhXhundzTk
1
2
58
Cornell Molecular Biology and Genetics department @CornellMBG has an open call for faculty applicants. Interested candidates please apply. All others please RT. Without a shadow of doubt I have loved it here.
1
16
28
This is such a big honor!!! I am enormously humbled and grateful 💜
@ednacukierman, Co-Leader of the Cancer Signaling and Microenvironment Research Program, and Co-Director of @FCCCGreenberg, has been named the inaugural holder of the Marvin & Concetta Greenberg Chair in Pancreatic Cancer Research. Congratulations! More: https://t.co/9ytZFB8DCp
53
23
223
The Nwosu Lab had its first group photo and lab outing yesterday. Huge excitement! I truly appreciate these energetic students that have come to work with me at this very early stage. The enthusiasm is overwhelming, the lab is set, and we have started experiments/learning.
3
2
53
Congratulations Eti!!
131 new research grants means 131 new approaches to find answers that help save lives from cancer! We are proud to support this OUTSTANDING group of new grantees including @ednacukierman, recipient of the @AmericanCancer-Wilmott Family Professorship in #PancreaticCancer Research
1
0
19
Congratulations to my friend Eti (@ednacukierman) the very deserving recipient of the @AmericanCancer Wilmott Family Professorship in #PancreaticCancer Research!! @FoxChaseCancer @billdahutmd @AmerCancerCEO @lwelmore0320
Researchers who are working on innovative discoveries & new ideas help move our mission forward. Our latest round of research & career development grants includes funding for 131 new grants totaling $64.5 million, funding investigators at 72 institutions: https://t.co/wRYHiaU96V
8
7
71
Open positions — 2 postdocs @NwosuLab. Please apply or share/retweet. Thank you!
1
37
39